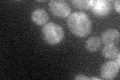
YGL145W
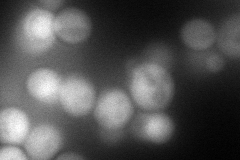
YGL145W
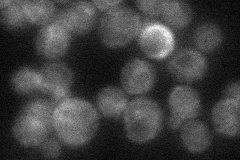
YGL145W
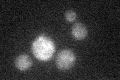
YGL145W

View description
Peripheral membrane protein required for fusion of COPI vesicles with the ER; prohibits back-fusion of COPII vesicles with the ER; forms a tethering complex with Sec39p and Dsl1p that interacts with ER SNAREs Sec20p and Use1p
Localization:
Intensity:
Fold change:
Significance:
-
C’ GFP library in SD
ER24.21 -
N' NOP1pr-GFP in SD

cytosol95.8201 -
N' TEF2pr-mCherry in SD
cytosol87.4276 -
N' NATIVEpr-GFP in SD
ambiguous,ER27.974 -
N' TEF2pr-VC and Cyto-VN in SD

cytosol39.5519 -
C’ GFP library in SD+DTT

ER20.670.85No -
C’ GFP library in SD+H2O2

ER21.980.9No -
C’ GFP library in Starvation Media
ER23.280.96No -
C’ GFP library on the background of Pup2-DaMP

ER -
C’ GFP library on the background of CCT mutant

ER21.65390.894406No
